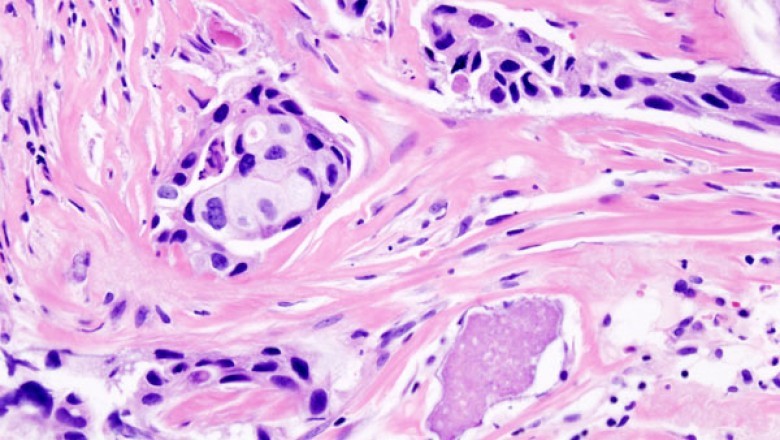

Anatomic Pathology is a branch of medicine that is mainly concerned with the diagnosis of an ailment
views
Anatomic Pathology
Anatomic Pathology is a part of medicine that's mainly concerned with the diagnosis of an ailment on the basis of the complete microscopic, macroscopic, biochemical, immunological, and cellular assessment of tissues and organs. The primary role of anatomic pathology is to identify abnormalities that can help diagnose disease and manage treatment. Anatomic pathologists investigate the results of disease on the human body via microscopic and autopsies examination of cells, tissues, and other specimens.
Anatomic Pathology can be used to ascertain the pathological nature of diseases by collecting and examining specimens to be able to assess and differentiate between diseases. Samples taken from your body may be collected for pathological examination underneath the general conditions or specific pathological circumstances. The pathological examinations of tissue, fluid, and organ tissues from the anatomic region are found in the length of diagnosing and treating disease. Since every type is different from one other, it is important to get specific sample for specific analysis.
The research of pathology is concerned with the description, diagnosis, and treatment of diseases, their causes, and treatments, including drugs. This branch of medicine has many subspecialties such as for example cardiovascular pathology, vascular pathology, dermatological pathology, hematology, neurology, infectious disease, gastroenterology, cardiology, orthopedics, and pediatric. This specialization relates to most of the branches of medicine and sciences. Anatomic pathology deals mostly with human body structure and is a vital section of emergency medicine.
Read More@ https://bit.ly/3yINCst